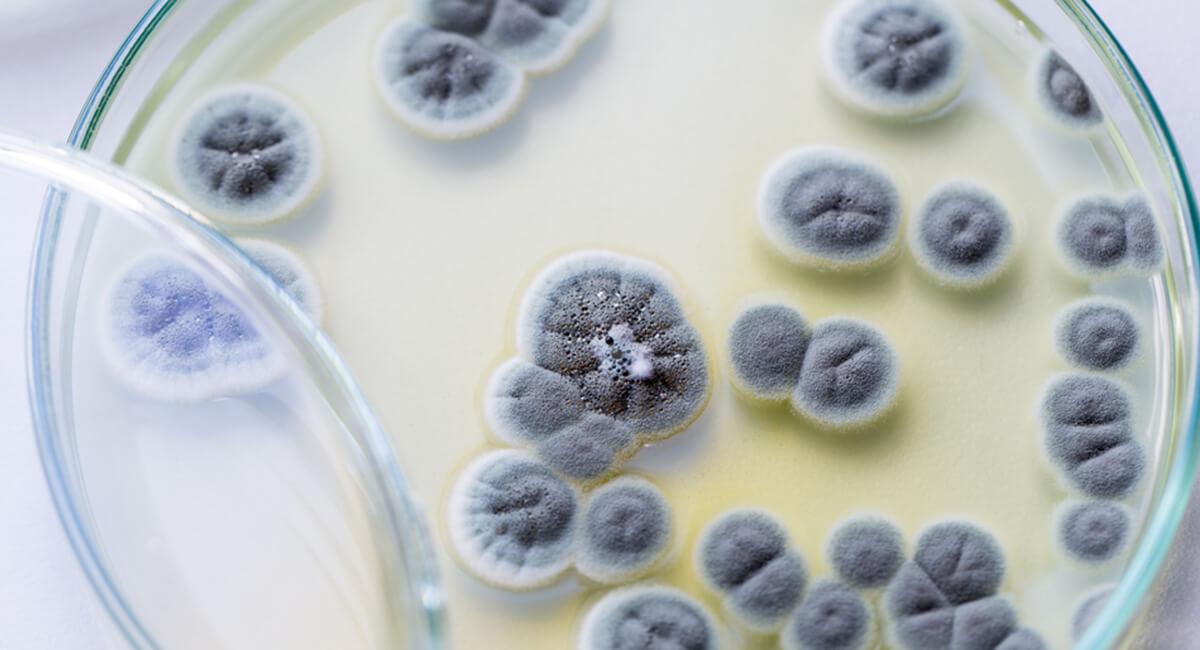
Foto de: Curso internacional en actualización y puesta al día en micología

🥇 Datos generales
La micología es la ciencia que se dedica al estudio de los hongos. Se trata de una de las áreas de la ciencia más extensas y diversificadas, que además aporta avances significativos a la investigación científica y al desarrollo tecnológico. Los hongos son organismos eucarióticos, ampliamente distribuidos en el ambiente y, generalmente, causan infecciones, como el pie de atleta o una infección por cándida.
Este programa formativo contiene material teórico y práctico que tiene el objetivo de que el alumno actualice sus conocimientos sobre el proceso de las técnicas de recogida de muestras micológicas y de los procesos analíticos. De esta forma, se asegurará la máxima calidad y eficiencia en cuanto al proceso analítico de muestras micológicas, utilizando para ello siempre la evidencia actual.
✔️ Requisitos de acceso
- Copia del DNI, TIE o Pasaporte.
📆 Plazo inscripción
La inscripción en esta actividad online permanecerá abierta hasta final de edición.
📝 Evaluación
La evaluación estará compuesta:
- 20 Preguntas tipo test.
- 5 Supuestos prácticos.
En caso de no superar el total de las evaluaciones conjuntamente, el alumno dispone de una segunda oportunidad sin coste adicional.
🎓 Destinatarios
A quién está dirigido el Curso internacional en actualización y puesta al día en micología
Este programa formativo online / a distancia esta dirigido a todo aquel personal de:
- Licenciados/as o graduados/as en farmacia.
- Biólogos en ciencias de la salud.
- Bioquímica.
- Técnicos superiores de laboratorio clínico y biomédico.
🎯 Objetivos
Objetivos generales
-
Adquirir conocimientos actualizados del alcance e implicación del proceso de las técnicas de recogida de muestras micológicas y de los procesos analíticos.
-
Asegurar la máxima calidad y eficiencia en cuanto al proceso analítico de muestras micológicas, utilizando siempre la evidencia actual al respecto.
Objetivos específicos
- Mejorar los procedimientos de trabajo en el laboratorio clínico hospitalario de acuerdo a las recomendaciones estandarizadas sobre micología.
- Adquirir los conocimientos y herramientas para llevar a cabo investigaciones en la materia, creando así nueva evidencia empírica.
- Optimizar la metodología, técnica e indicaciones analíticas para minimizar las fuentes de error que pueden tener lugar en el desarrollo analítico de pruebas micológicas.
- Establecer unos estándares mínimos de calidad para el laboratorio en los que se definirán los procesos de análisis clínicos y objetivos para cada una de las muestras biológicas que constituyen el catálogo de prestaciones del laboratorio hospitalario.
- Instaurar las novedades tecnológicas y científicas en relativas a micología y todos los procesos y consideraciones bioquímicas actuales.
- Promover el uso de las guías de práctica clínica basadas en la evidencia en micología.
- Optimizar la metodología y técnica analítica, indicación y selección diagnóstica, las fuentes de error que pueden tener lugar en el desarrollo analítico de pruebas micológicas.
Plan de estudios
Tema I. Micología clínica:
- Estructura de la célula fúngica. Reproducción.
- Taxonomía fúngica. Grupos de interés clínico.
- Enfermedades micóticas.
- Micosis superficiales.
- Tiñas.
- Candidiasis.
- Pitiriasis.
- Tinea negra.
- Piedras.
- Micosis subcutáneas.
- Micosis profundas.
- Coccidioidomicosis.
- Micosis superficiales.
- Muestras para estudio micológico.
- Recogida, transporte y procesamiento de muestras para el estudio de infecciones fúngicas.
- Muestras para estudio de micosis superficiales.
- Muestras para estudio de micosis subcutáneas.
- Muestras para estudio de micosis profundas.
- Técnicas básicas en micología.
- Estudio de micosis superficiales.
- Estudio de micosis subcutáneas.
- Estudio de micosis profundas.
- Estudio de micosis oportunistas.
- Resumen.
- Autoevaluación.
- Bibliografía.
Sobre los Profesores

Rafael Ceballos Atienza
Tutor de esta Formación
Doctor en Medicina y Cirugía por la Universidad de Granada (España).

Sonia Baeza García
Tutora de esta Formación
Graduada en Psicología por la Universidad de Granada (España) y Técnico Superior en Salud Ambiental.

Juan Ramón Ledesma Sola
Tutor de esta Formación
Técnico Auxiliar en cuidados de enfermería.

Inmaculada Gonzalez Funes
Tutora de esta Formación
Graduada en Enfermería por la Universidad de Jaén (España).